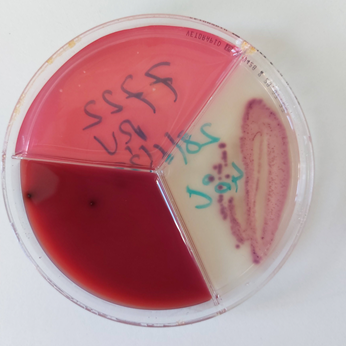

Workshop On practice culture (ILVO)
Volg een workshop over het selectief behandelen van klinische mastitis in Melle.

Raadpleeg ons overzicht met de juiste contactinformatie per thema, zodat je zo snel mogelijk een antwoord krijgt.